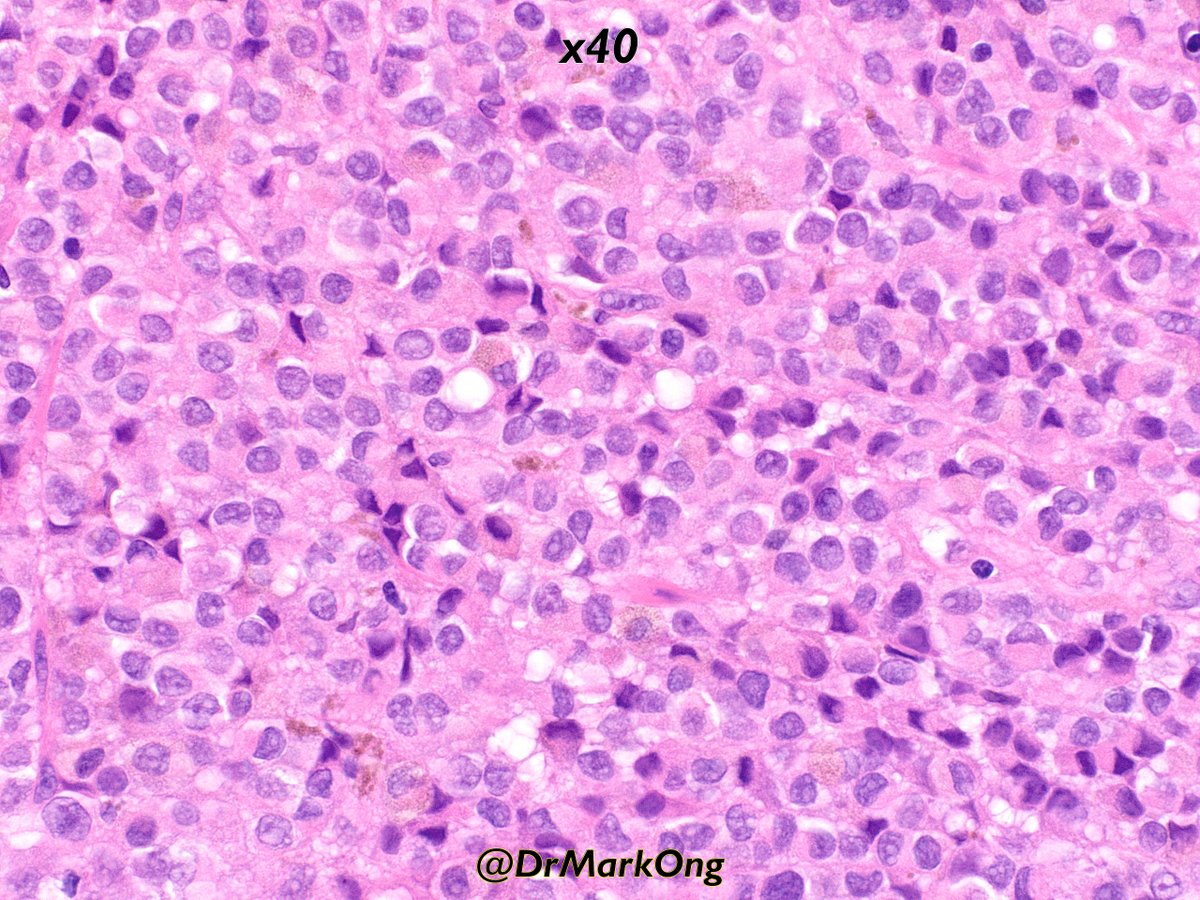
Mark Ong (@drmarkong) on Twitter photo Duodenal mass.
Can you make a diagnosis on H&E alone?
#GIpathology #pathology Duodenal mass.
Can you make a diagnosis on H&E alone?
#GIpathology #pathology

Radmila Jankovic
@radmilamd
pathologist
ID: 187561986
06-09-2010 15:37:16
1,1K Tweet
291 Followers
532 Following


75 y/old, retroperitoneal lesion,H&E,would you like to propose any IHC to support the final diagnosis? Fiona Maclean A. Cristina Vargas Tristan Rutland MBBS FRCPA IFCAP Carlos Monteagudo Cleo Romagosa IMPERAS Henry YANG Sumanta Das @kells108 Anatomía Patológica, Hospital La Fe AP Hospital 12 de Octubre VallHebronPath








New study online ahead of print Am J Surg Pathol introducing a new entity in thymic pathology!: Desmoplastic Adamantinoma-like Thymic Carcinoma #pathtwitter #surgpath #mediastinum #thymus



Keith Siau Pyostomatitis vegetans is a rare and unusual disorder of the oral cavity,characterized by erythema and edema of the mucosa and numerous small,superficial yellow pustules. Its significance lies in its association with inflammatory disease of the bowel,either UC or Crohn's disease.


We are excited to announce that the BioengineeredTumor Project officially started on January 1, 2024! The project is supported by Fond za nauku Republike Srbije and is dedicated to developing a reliable platform for cancer research and drug testing. Yesterday’s kick-off meeting was a success!